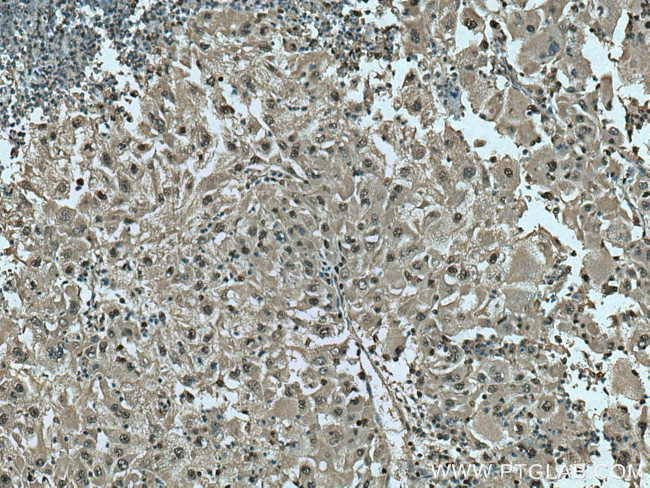
PSMB10 Antibody in Immunohistochemistry (Paraffin) (IHC (P))

Search
Proteintech
PSMB10 Polyclonal Antibody
{{$productOrderCtrl.translations['antibody.pdp.commerceCard.promotion.promotions']}}
{{$productOrderCtrl.translations['antibody.pdp.commerceCard.promotion.viewpromo']}}
{{$productOrderCtrl.translations['antibody.pdp.commerceCard.promotion.promocode']}}: {{promo.promoCode}} {{promo.promoTitle}} {{promo.promoDescription}}. {{$productOrderCtrl.translations['antibody.pdp.commerceCard.promotion.learnmore']}}
产品信息
15976-1-AP
种属反应
宿主/亚型
分类
类型
抗原
偶联物
形式
浓度
规格
纯化类型
保存液
内含物
保存条件
运输条件
产品详细信息
Immunogen sequence: MLKPALEPR GGFSFENCQR NASLERVLPG LKVPHARKTG TTIAGLVFQD GVILGADTRA TNDSVVADKS CEKIHFIAPK IYCCGAGVAA DAEMTTRMVA SKMELHALST GREPRVATVT RILRQTLFRY QGHVGASLIV GGVDLTGPQL YGVHPHGSYS RLPFTALGSG QDAALAVLED RFQPNMTLEA AQGLLVEAVT AGILGDLGSG GNVDACVITK TGAKLLRTLS SPTEPVKRSG RYHFVPGTTA VLTQTVKPLT LELVEETVQA MEVE (1-273 aa encoded by BC017198)
靶标信息
The 20S proteasome is a protease complex that is responsible for cytosolic protein degradation and generation of peptide ligands for major histocompatibility complex (MHC) class I molecules, either in their final form or in the form of amino-terminally extended precursors. Upon IFN-gamma stimulation of cells, three constitutively expressed subunits of the 20S proteasome are replaced by inducible subunits LMP2 (low-molecular mass polypeptide 2), LMP7, and MECL-1 (multicatalytic endopeptidase complex-like-1, LMP10). LMP2, LMP7, and MECL-1 subunits form immunoproteasomes, which are associated with more efficient class I antigen processing and presentation. Independent assortment of LMP-2, LMP-7, and MECL-1 into different proteasome complexes can lead to 36 unique proteasome subsets, which may mediate differences in the cleavage specificities/cleavage motifs of proteins subject to constitutive- and immuno-proteasomes.
仅用于科研。不用于诊断过程。未经明确授权不得转售。
生物信息学
蛋白别名: Low molecular mass protein 10; Macropain subunit MECl-1; MGC1665; Multicatalytic endopeptidase complex subunit MECl-1; OTTHUMP00000174858; proteasome (prosome, macropain) subunit, beta type, 10; proteasome catalytic subunit 2i; Proteasome MECl 1; Proteasome MECl-1; proteasome subunit beta 10; proteasome subunit beta 7i; Proteasome subunit beta type-10; Proteasome subunit beta-2i; proteasome subunit beta2i; proteasome subunit MECL1; PSMB 10; PSMB10; unnamed protein product
基因别名: beta2i; IMD121; LMP10; MECL1; PRAAS5; PSMB10
UniProt ID: (Human) P40306
Entrez Gene ID: (Human) 5699